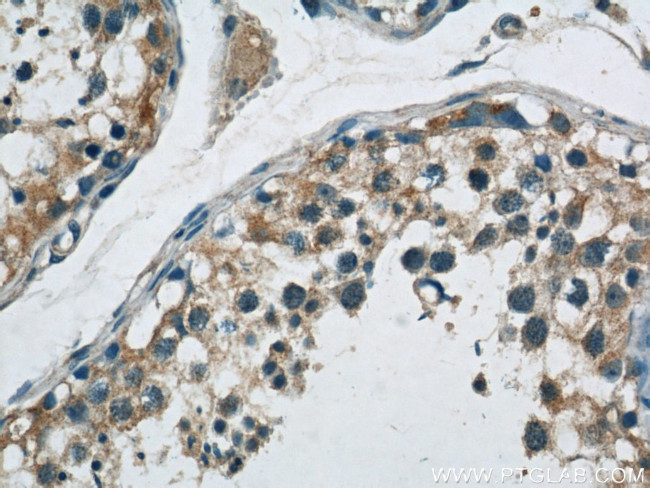
ABI2 Antibody in Immunohistochemistry (Paraffin) (IHC (P))

Search
Proteintech
ABI2 Polyclonal Antibody
{{$productOrderCtrl.translations['antibody.pdp.commerceCard.promotion.promotions']}}
{{$productOrderCtrl.translations['antibody.pdp.commerceCard.promotion.viewpromo']}}
{{$productOrderCtrl.translations['antibody.pdp.commerceCard.promotion.promocode']}}: {{promo.promoCode}} {{promo.promoTitle}} {{promo.promoDescription}}. {{$productOrderCtrl.translations['antibody.pdp.commerceCard.promotion.learnmore']}}
产品信息
14890-1-AP
种属反应
宿主/亚型
分类
类型
抗原
偶联物
形式
浓度
规格
纯化类型
保存液
内含物
保存条件
运输条件
产品详细信息
Immunogen sequence: MAELQMLLE EEIPGGRRAL FDSYTNLERV ADYCENNYIQ SADKQRALEE TKAYTTQSLA SVAYLINTLA NNVLQMLDIQ ASQLRRMESS INHISQTVDI HKEKVARREI GILTTNKNTS RTHKIIAPAN LERPVRYIRK PIDYTILDDI GHGVKVSTQN MKMGGLPRTT PPTQKPPSPP MSGKGTLGRH SPYRTLEPVR PPVVPNDYVP SPTRNMAPSQ QSPVRTASVN QRNRTYSSSG SSGGSHPSSR SSSRENSGSG SVGVPIAVPT PSPPSV (1-275 aa encoded by B C001439)
靶标信息
ABI2 may act in regulation of cell growth and transformation by interacting with nonreceptor tyrosine kinases ABL1 and/or ABL2. ABI2 is a part of the WAVE complex that regulates lamellipodia formation. The WAVE complex regulates actin filament reorganization via its interaction with the Arp2/3 complex. It regulates ABL1/c-Abl-mediated phosphorylation of MENA.
仅用于科研。不用于诊断过程。未经明确授权不得转售。
生物信息学
蛋白别名: Abelson interactor 2; Abi-2; Abi-2b; abl binding protein 3; Abl interactor 2; Abl-binding protein 3; abl-interacting protein 1 (SH3-containing protein); abl-interactor protein 2b; AblBP3; arg protein tyrosine kinase-binding protein; Arg-binding protein 1; ArgBP1; thyroid hormone responsive protein; unnamed protein product
基因别名: 8430425M24Rik; ABI-2; ABI2; ABI2B; AblBP3; AI839867; AIP-1; AIP1; argBP1; ARGBPIA; argBPIB; C130078H13; SSH3BP2
UniProt ID: (Human) Q9NYB9, (Mouse) P62484
Entrez Gene ID: (Human) 10152, (Mouse) 329165, (Rat) 286928